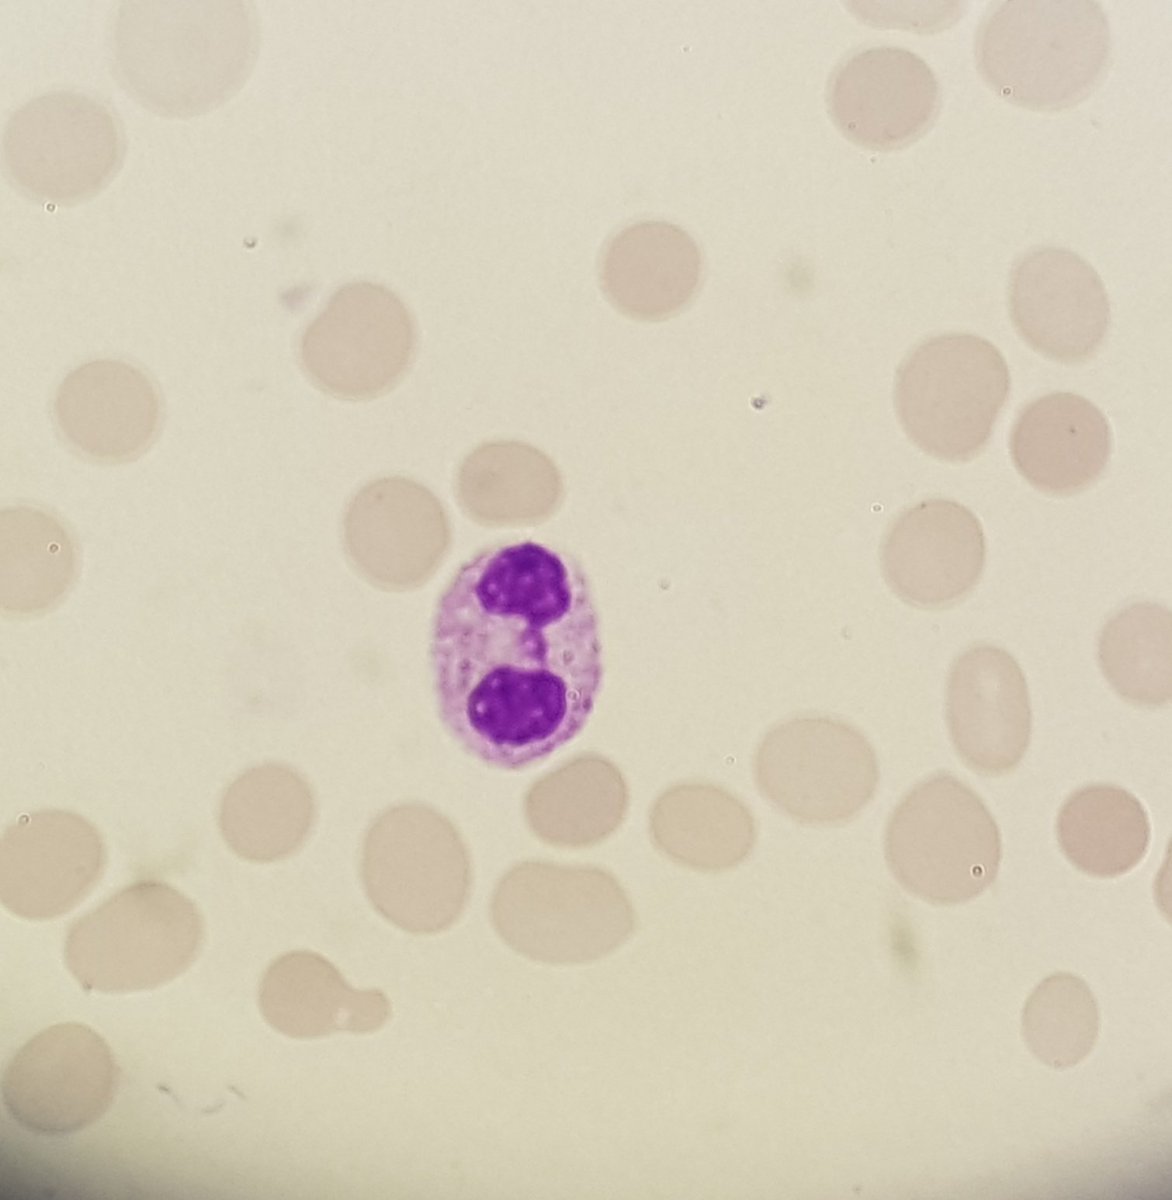

LaboATLAS @LaboATLAS
LaboATLAS es un atlas online de microfotografía de laboratorio clínico con finalidad docente. laboatlas.com A Coruña, Spain Joined May 2017-
Tweets408
-
Followers841
-
Following129
-
Likes46
Sorafenib maintenance after transplant has shown to be effective in decreasing chance of relapse for patients with acute myeloid leukemia: @smu_medical buff.ly/3hifID5 #sorafenib #leukemia #acute #myeloid #AML #chemotherapy #cancer #oncology #oncologist #hematology
Pretty Mott Cell 💖 #hemepath
All the images Belong to the same bone marrow slide. 40y female with Unclassified MDS/MPN. I felt it Could work Like a hemepath Captcha. 😃Please select the images with megakaryocytes (dysplastic or not) #hemepath #MDS #MPN #Dysplasia
SH #Quickbyte Marked cytoplasmic vacuolation in granulocytic and erythroid precursors is often associated with copper deficiency. This can mimic MDS morphologically with prominent dysplasia and RS - careful not to overlook a benign diagnosis! #hemepath #MDS #CopperDeficiency
My #hemepath case of the month: older man found to have ⬆️ WBC due to ⬆️ lymphs (35x10e9/L). Asymptomatic, w/ imaging later showing mild splenomegaly and no LAD. PB images:
Leukemia day! Auer Rods! #hemepath
Interesting trivia: every couple applying for a marriage license in Iran (my home country) is legally required to get tested for #thalassemia minor in an effort to prevent homozygous offsprings. #geneticscreening #heme #hemepath
Interesting trivia: every couple applying for a marriage license in Iran (my home country) is legally required to get tested for #thalassemia minor in an effort to prevent homozygous offsprings. #geneticscreening #heme #hemepath
Parasite Case of the Week 564 is up – found on blood smear: parasitewonders.blogspot.com/2019/10/case-o… How would you report? #asmclinmicro #MayoClinMicro #mayopath #parasites #path2path #pathology @JMGardnerMD @mayocliniclabs @ASTMH @Pathologists @AmSocParasit @LSHTM
Found this little guy hiding amongst the thousands of neutrophils, myelocytes and metamyelocytes. Pseudo-Gaucher cell which can be seen in CML. #hemepath
Comenzamos la semana con el “Comité de Diagnóstico Hematológico Integrado” en @Hospital_FJD con un caso de un síndrome hemofagocítico #Hematología #AnatomíaPatológica #Citometría #Citogenética #BiologíaMolecular
A 24 yrs lady presenting with generalized petechiae and menorrhagia. Clinical suspicion was ITP. Her PBF reveals the presence of these hypergranular giants. A masquarading hypergranular acute promyelocytic leukemia complicated by DIC! #pathology #hemepath #APL #DIC
In continuation of the beautiful case @PathologySayah shared, I add hairy cell morphology on smear #hemepath #pathology #hematology #leukemia #bloodcancer #hemepathMDA
In continuation of the beautiful case @PathologySayah shared, I add hairy cell morphology on smear #hemepath #pathology #hematology #leukemia #bloodcancer #hemepathMDA https://t.co/Dc8JvVDtjj
Dysplastic feast: Pseudo Pelger-Huët anomaly in #mds #hemepath #morphology #hematology
So this is interesting looking.... #hemepath #pathology #thisisntright
1st presentation of Chronic Myeloid Leukaemia Chronic Phase. Pic1 Shows the range of cells in the PBfilm which is leucoerythoblastic. Pic2 Harlequin cell-eosinophil with basophilic granules Pic3 Degranulated basophil #chronicmyeloidleukaemia #hemepath #haematology #hematology
La web de LaboATLAS está de nuevo disponible. ¡Gracias por vuestra paciencia! :) laboatlas.com
Lamentablemente LaboAtlas no está disponible porque nuestro servidor web está teniendo fallos técnicos. Estamos a la espera de que nos den una solución. Sentimos las molestias y esperamos que nos lo arreglen pronto.

mICROBIO @mICROBIOsh
49K Followers 3K Following 🔎Un ser vivo diminuto dotado de individualidad. 🤺El azote de Dios desde tiempos inmemoriales. 🔬Antonie van Leeuwenhoek mi padre.
SEQC_ML @SEQC_ML
3K Followers 201 Following Sociedad Española de Medicina de Laboratorio. Formación, publicaciones, becas y ofertas de empleo para especialistas en Análisis Clínicos y Bioquímica Clínica.
Raquel G. Molina @raquelgmol
283 Followers 548 Following Química Residente de Análisis Clínicos | Vocal CN de AC y Comité de Comunicación @SEQC_ML | Periodista científica
Santiago Prieto @SantiagoPM50
1K Followers 3K Following AEBM-Medicina de Laboratorio Trabajando en lo que me gusta. Mis opiniones son personales
Manuel González de A... @manu_microypara
745 Followers 869 Following Biochemist at @unicomplutense & @helsinkiuni. Clinical Microbiologist & Parasitologist at @microRyC. Phage enthusiast. #PhageTherapy
labclinorg @labclinorg
912 Followers 734 Following Cuenta de https://t.co/2KP7ObzhDF punto de encuentro y promoción del laboratorio clínico y sus profesionales.
@sehh_es @sehh_es
12K Followers 4K Following Twitter oficial de la Sociedad Española de #Hematología y #Hemoterapia (SEHH) #HematoEnRed #HematoAvanza #SEHHematología #SEHHCuidaTuSangre #SEHHContigo
Miguel Angel @AngelKansasii
2K Followers 1K Following Mis pasiones: familia, medicina y... Betis. Defensor del laboratorio clínico, especialmente de la Microbiología. Sin respeto, no se puede llegar a la razón.
Rodolfo Mazzucco @RodolfoMazZ
188 Followers 263 Following
monnerij @monnerij
0 Followers 476 Following
Belén @bln400
69 Followers 101 Following
Pumpkin_queen @Pumpkin56269050
0 Followers 9 Following
Roger @Roger13330590
47 Followers 1K Following
Jennifer Yvonne @JYvonne1410
1 Followers 4 Following
CARLOS FIGUEROA @CARLOSF33210822
4 Followers 306 Following
lulu69 @JavierHill088
4 Followers 920 Following Amante del arte en general, canto🎤, bailo🕺, escribo✍️, dibujo🖍️, pinto🎨 y actuó🎭. Los esfuerzos valen la pena 💪🏼 No te desanimes 😊
Andrés @Andrs44302785
9 Followers 324 Following
Edna Isabel Leiva @LeivaEdna
0 Followers 13 Following
Gabrielaa @gabiiml7
12 Followers 23 Following
Beny D'zul @benydzul
0 Followers 6 Following
ingrid @ingru76
79 Followers 507 Following
Loke Cóndor @loke68500
0 Followers 9 Following
Dorelly Zarate @Zdorelly
0 Followers 21 Following
Azul ♡ @azul0713
12 Followers 136 Following
Adriana Montero Castr... @Montero029515
0 Followers 14 Following
Keyling Matute @ma96909
0 Followers 2 Following
Guadalupe Córdova @Lupisky
426 Followers 4K Following ENCB-IPN. Investigación, enseñanza. Micribiología. Bacteriología Médica
Yolanda Ramírez Garc... @Yolanda39410138
0 Followers 4 Following
Jesús P @j_wn93
10 Followers 312 Following
Alejandro Hdez @AlejandroHde
11 Followers 218 Following
Cristal Dor @dorado_cristal
0 Followers 10 Following
Amouri mariem @AMouri221998
0 Followers 26 Following
🍁🎃🍂Spooky Ko... @jon_fenix
372 Followers 2K Following Bioquímico con un toque de neurocientífico. Profesor de Laboratorio Clínico y Anatomía patológica. DnD. Sci-fi. Cosmere. Worldbuilder. He/him. 🏳️🌈.
Saida Abassi @SaidaAbass92282
0 Followers 14 Following
SARA R.L @sara6296
786 Followers 762 Following Farmacéutica en mis ratos libres; Análisis Clínicos-Hospital Clínico Universitario de Valladolid; Mamá de Roma 🐶🤎
teff @teff_fi
1 Followers 7 Following
Ara Olmo @Aravet847
0 Followers 160 Following
una broma @daughter_horror
73 Followers 201 Following
Alba 🙊♀ @albusiaig
86 Followers 467 Following Yo de mayor quiero ser valiente 💪 // BIR Análisis Clínicos🔬
Carlos Cool Mendez @cool_mendez
94 Followers 1K Following Amante del la tecnología, Anime y Manga, o cualquier cosa que me parezca interesante o que llame mi atención.
Moly @cherrywine1111
2 Followers 6 Following
Gustavo Mendoza @Amm628Mendoza
0 Followers 10 Following
laura @lau_r_gh
0 Followers 22 Following
Rita Aguilar @RitaAguilar9
611 Followers 1K Following Me gustan los riñones, correr y todos los deportes 🦔
Miriam Garcia Bosca @BoscaMiriam
0 Followers 11 Following
Jicaro @izumiumi01
7 Followers 138 Following Fanática de la lectura que libere mi imaginación y amante de los gatos :3 🫶🏽👊🏽🇵🇪
lucecu @oalxubedolucecu
261 Followers 3K Following
fernanda U_U @mafer707_u
6 Followers 42 Following
Nanchu @Nanchu21634965
0 Followers 48 Following
Maria Jose Alvarez Lo... @MJALVAREZLOPEZ1
89 Followers 673 Following Disfrutar de la alegría ajena es la clave de la felicidad🍀
Osiel @Osiel21397820
0 Followers 3 Following
SEQC_ML @SEQC_ML
3K Followers 201 Following Sociedad Española de Medicina de Laboratorio. Formación, publicaciones, becas y ofertas de empleo para especialistas en Análisis Clínicos y Bioquímica Clínica.
microBIO @microBIOblog
85K Followers 2K Following Divulgación científica, noticias y curiosidades sobre virus, bacterias y otros temas relacionados con la ciencia. No discuto en Twitter. (Ignacio López-Goñi).
SEIMC @SEIMC_
24K Followers 581 Following Cuenta oficial de la Sociedad Española de Enfermedades Infecciosas y Microbiología Clínica
Blood Journals Portfo... @BloodPortfolio
54K Followers 431 Following Portfolio of ASH journals including Blood, Blood Advances, Blood Global Hematology, Blood ICT, Blood Neoplasia, Blood RCI, and Blood VTH.
Santiago Prieto @SantiagoPM50
1K Followers 3K Following AEBM-Medicina de Laboratorio Trabajando en lo que me gusta. Mis opiniones son personales
EFLM @_EFLM
2K Followers 56 Following Twitter account of the European Federation of Clinical Chemistry and Laboratory Medicine.
Raul Cordoba, MD, PhD @DrRaulCordoba
11K Followers 5K Following Hematologist. Board member @sehh_es. @EHA_hematology SWG Committee member. @ASH_hematology International Member Committee
Eduardo Alcaraz, MD P... @edusqo
8K Followers 189 Following #Pathologist #CytoPath @SimInPath📱@HolopathVR🥽 #FioNA's 💉 inventor #DigitalPathology 🔬🖥 #Simulation #MedEd Anatomía Patológica - patólogo profesor @UMU
José Ant. Marcos @jamr_cho2
4K Followers 1K Following Farmacéutico Hospitalario en @HUVMacarena. Oncología-Hematología. BCOP. Secretario de la @SEFH_ Mis opiniones son personales
@sehh_es @sehh_es
12K Followers 4K Following Twitter oficial de la Sociedad Española de #Hematología y #Hemoterapia (SEHH) #HematoEnRed #HematoAvanza #SEHHematología #SEHHCuidaTuSangre #SEHHContigo
SEAP-IAP @SEAP_IAP
6K Followers 345 Following Sociedad Española de Anatomía Patológica-División Española de la International Academy of #Pathology #AnatomíaPatológica #patólogo Spanish Society of #Pathology
SEInmunología @SEinmunologia
10K Followers 415 Following Cuenta oficial de la Sociedad Española de #Inmunología (SEI). ¡Entérate de todas las noticias inmunológicas🛡!
Philips España @PhilipsSpain
28K Followers 24K Following Cuenta oficial de Philips España. Todas las novedades sobre nuestra marca relacionadas con #Innovación, #Sostenibilidad y #Salud. #BetterCareForMorePeople
Judith Ferry @judith_ferry
3K Followers 37 Following #JAF is Director of Hematopathology, MGH, Prof of Pathology, Harvard, mother of Cindy and Debbie, native of New Orleans, now at home at Boston’s waterfront.
Jaya Balakrishna MD @JBalakrishnaMD
2K Followers 987 Following Hematopathologist, researcher and watercolor artist. Tweets are not medical advice
Javier Peteiro Carte @peteirocartelle
273 Followers 170 Following
LAHT @LAHTsrl
33 Followers 52 Following Laboratorio de Hemostasia y Trombosis - Laboratorio de Análisis Clínicos y Bacteriológicos especializado en Hemostasia y Trombosis ⚗️🧪🧫🧬🔬💉
Elsevier Español @Elsevier_Es
28K Followers 12K Following Canal oficial. Empresa de análisis de información global. Líder mundial en edición técnica, #SolucionesClínicas y #EducaciónMédica @CompleteAnatomy @OsmosisMed
Siemens Healthineers @SiemensHealthES
21K Followers 5K Following Canal oficial de Siemens Healthineers en español. Somos líderes en tecnología sanitaria y aquí te contamos nuestras últimas innovaciones y noticias destacadas
Escuela Andaluza SP @EASPsalud
19K Followers 2K Following Para el desarrollo de la formación, la consultoría, la investigación y la cooperación internacional en Salud Pública y Gestión Sanitaria
IBiS @ibis_sevilla
6K Followers 2K Following Cuenta oficial del Instituto de Biomedicina de Sevilla, espacio de investigación multidisciplinar sobre patologías prevalentes, con transferencia a la clínica.
Fundación Progreso y... @FProgresoysalud
9K Followers 1K Following Gestión y Apoyo a la I+D+i en Biomedicina, Formación y Evaluación de Competencias Profesionales y Desarrollo de TIC. Consejería de Salud y Consumo. #Andalucía
Espacios SaludInvesti... @eSaludInvestiga
7K Followers 963 Following Plataforma para la interacción y el intercambio de conocimientos en el ámbito de la I+D+i en Salud gestionada por la Fundación Progreso y Salud.
ibs.GRANADA @ibsGRANADA
11K Followers 4K Following Instituto de Investigación Sanitaria creado por la colaboración entre la Universidad de Granada y los Hospitales de Granada
LabMedica.com @LabMedica
1K Followers 3 Following A global news site providing clinical lab professionals with the latest in clinical chemistry, genetic testing, microbiology, immunology and more.
Labroots @Labroots
12K Followers 461 Following Labroots is the leading scientific social networking website, producer of educational virtual events and webinars, and your source for trending science news.
Labroots Clinical & M... @Diagnostics_LR
2K Followers 245 Following The Official @Labroots Clinical & Molecular Diagnostics Page! We cover topics such as virology, blood screening, genomics, oncology, and microbiology. 🧫
Dr. Shannon Haymond @SHaymondSays
1K Followers 869 Following Prof Pathology @NUFeinbergMed & Chief DPLM @LurieChildrens, tweets my own.
Clinical Laboratory N... @CLN_ADLM
10K Followers 635 Following Published by the Association for Diagnostics & Laboratory Medicine (ADLM, formerly AACC)
Clinical Chemistry @Clin_Chem_ADLM
12K Followers 1K Following Official Twitter of the journal Clinical Chemistry. Submit now: https://t.co/XPrYtkzgcJ
Asociación Española... @AEGHgenetica
5K Followers 502 Following La AEGH está formada por más de 1.300 profesionales que se dedican a la Genética Humana. 🧬 Luchamos por el reconocimiento de la #EspecialidadGenéticaYA
Lady Hemato @ladyhemato
639 Followers 39 Following Para aprender hematología ♥️ #hematología #hematology #medicinainterna #ENARM
Bobbi Pritt, MD @ParasiteGal
13K Followers 198 Following Professor of #Pathology @mayocliniclabs @mayoclinic, specializing in ID Path, #parasites! and vectorborne diseases. Tweets are my own, not medical advice
Fundación Bioquímic... @fbioquimica
2K Followers 88 Following Entidad de bien público destinada a plasmar en acciones concretas los avances de las Ciencias Bioquímicas en beneficio de la salud de la población.
BioLab News @BioLab_
132 Followers 63 Following Somos un medio digital de noticias que facilita conexiones y genera colaboración entre los distintos actores del ámbito de los laboratorios analíticos.
analisisbioquimicos @analisisbioquim
1K Followers 1K Following Una WEB de Servicio a la Comunidad con información relacionada con los Análisis Bioquímicos. Apoyada y sostenida por FABA.
Clin Chem Lab Med @cclm_degruyter
2K Followers 412 Following Monthly journal devoted to all aspects of clinical chemistry and laboratory medicine. Affiliated with #EFLM. Submissions at: https://t.co/VTksNN0eET
IFCC&LM @IFClinChem
4K Followers 466 Following International Federation of Clinical Chemistry and Laboratory Medicine
Noa🌱 @fagocitor
6K Followers 226 Following
Leucocito Curioso @LeucoCurioso
9K Followers 735 Following Salí de mi humano durante una hemorragia y desde entonces vago por el Universo. Narro aquí mis aventuras y pensamientos.
Hemomadrid @hemomad
631 Followers 589 Following Equipo de Hematólogos. Consulta Online. Anticoagulación. Transfusión. Fertilidad. https://t.co/7UvEhUJKRp https://t.co/eZarZdbRLN
Nature Medicine @NatureMedicine
352K Followers 255 Following Nature Medicine is a research journal devoted to publishing the latest advances in translational and clinical research for scientists and physicians.
AEC2 @aecomcientifica
136K Followers 1K Following La Asociación Española de Comunicación Científica (AEC2) agrupa a profesionales de la comunicación de ciencia, tecnología, salud y medio ambiente desde 1973.
PROA_Marañón @PROA_maran
4K Followers 158 Following Tto antimicrobiano y Dco EEII. Antimicrobial Stewardship Program and Infectious Diseases. El uso prudente de Ab protege a tus pacientes #PROA. Cuenta no oficial
Diego García Martín... @micromunidad
2K Followers 591 Following Microbiólogo Clínico en Tenerife (Spain). Antes Micromunidad. Ahora Sensible y Resistente podcast. Vamos a hacerlo. Si hago RT es pa leer el estudio luego.
Jesus Rodriguez Baño @jesusrbano
8K Followers 1K Following Infectious diseases, family, friends, science and arts. Working at HUVM, University of Sevilla and IBiS. ESCMID Past President but here only my own opinions
Hematologia HUSE @HematoHUSE
697 Followers 286 Following Servicio de Hematología y Hemoterapia, Hospital Universitario Son Espases
Kattia Mena @kattsmena
136 Followers 329 Following Viviendo con ilusión. No dejo para mañana lo que me gusta hacer hoy! #Heaprendidoaamar #Familia #LaboratoriosClínicos #Calidad
vicente morales elipe @MoralesElip
123 Followers 80 Following Jubilado 2/23 después de 44 años en los Laboratorios clínicos.Ahora cocino, leo,voy a la Universidad de Mayores, y sigo amando a mi mujer.
ASH @ASH_hematology
72K Followers 2K Following The American Society of Hematology (ASH) is the world's largest professional society concerned with the causes and treatments of blood disorders.
Ciencia Plus @cienciaplus
432K Followers 727 Following Actualidad científica global editada en español por Europa Press. Vídeos en https://t.co/U0ssr68Mcj .
Chema Cepeda @chemacepeda
17K Followers 8K Following ·Somos lo que conectamos· Podcast 🎙@Conectantes #saludconectada #saluddigital #innovación 🚑 #SVAE #UEnE
🧠Teresa Pérez @EnfSaludDigital
22K Followers 4K Following 👩🏼⚕️#Enfermera #AtencionPrimaria 📲#SaludDigital 👩🏼💻 #CuidandolaMente #ConexionConsciente
M.Patrocinio Chueca @Pchuecar
998 Followers 1K Following Dra.Medicina y Quimico.Consultor experto C. Comunicacion SEMEDLAB, miembro del WG IANT, del Consejo Editorial del DIV de la IFCC.
Javier Cepeda piorno @jacepi2002
408 Followers 872 Following Farmacéutico Especialista en Análisis Clínicos (PhD), en continuo aprendizaje.